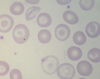

Kartagener’s syndrome
Kartagener’s syndrome (also known as primary ciliary dyskinesia) was first described in 1933 and most frequently occurs in examinations due to its association with dextrocardia (e.g. ‘quiet heart sounds’, ‘small volume complexes in lateral leads’)
Pathogenesis
dynein arm defect results in immotile cilia
Features
dextrocardia or complete situs inversus
bronchiectasis
recurrent sinusitis
subfertility (secondary to diminished sperm motility and defective ciliary action in the fallopian tubes)
Progressive multifocal leukoencephalopathy (PML)
widespread demyelination
due to infection of oligodendrocytes by JC virus (a polyoma DNA virus)
symptoms, subacute onset : behavioural changes, speech, motor, visual impairment
CT: single or multiple lesions, no mass effect, don’t usually enhance. MRI is better - high-signal demyelinating white matter lesions are seen
CNS Cryptococcus on CT head?
CT: meningeal enhancement, cerebral oedema
CNS lymphoma on CT ?
CT: single or multiple homogenous enhancing lesions
CNS toxoplasmosis on CT head?
usually single or multiple ring enhancing lesions, mass effect may be seen
how is corrected calcium calculated?
measured calcium + (40 - serum albumin) X 0.027
Monitoring of Paget’s disease?
Monitor ALP every 6-12 months
Pagets disease investigations?
- bloods
raised alkaline phosphatase (ALP)
calcium and phosphate are typically normal. Hypercalcaemia may occasionally occur with prolonged immobilisation - other markers of bone turnover include
procollagen type I N-terminal propeptide (PINP)
serum C-telopeptide (CTx)
urinary N-telopeptide (NTx)
urinary hydroxyproline - x-rays
plain radiographs are the first-line investigation and are usually diagnostic
osteolysis in early disease → mixed lytic/sclerotic lesions later
skull x-ray: thickened vault, osteoporosis circumscripta - bone scintigraphy
increased uptake is seen focally at the sites of active bone lesions
Management of paget’s?
indications for treatment include
bone pain
skull or long bone deformity
fracture
periarticular Paget’s
bisphosphonate (either oral risedronate or IV zoledronate)
calcitonin is less commonly used now
Diagnosis of MGUS ?
M protein level < 30g/l
<10% plasma cells on bone marrow investigation
no end organ damage associated with myeloma
Major criteria
Plasmacytoma (as demonstrated on evaluation of biopsy specimen)
30% plasma cells in a bone marrow sample
Elevated levels of M protein in the blood or urine
Minor criteria
10% to 30% plasma cells in a bone marrow sample.
Minor elevations in the level of M protein in the blood or urine.
Osteolytic lesions (as demonstrated on imaging studies).
Low levels of antibodies (not produced by the cancer cells) in the blood.
Renal Tubular acidosis
Tyep1
Type 2
Type 3
Type 1 RTA (distal)
inability to generate acid urine (secrete H+) in distal tubule
causes hypokalaemia
complications include nephrocalcinosis and renal stones
causes include idiopathic, rheumatoid arthritis, SLE, Sjogren’s, amphotericin B toxicity, analgesic nephropathy
Type 2 RTA (proximal)
decreased HCO3- reabsorption in proximal tubule
causes hypokalaemia
complications include osteomalacia
causes include idiopathic, as part of Fanconi syndrome, Wilson’s disease, cystinosis, outdated tetracyclines, carbonic anhydrase inhibitors (acetazolamide, topiramate)
Type 4 RTA (hyperkalaemic)
reduction in aldosterone leads in turn to a reduction in proximal tubular ammonium excretion
causes hyperkalaemia
causes include hypoaldosteronism, diabetes
Prognostic scoring for WALDENSTROMS?

Acute angle closure glaucoma features and managment
Features
severe pain: may be ocular or headache
decreased visual acuity
symptoms worse with mydriasis (e.g. watching TV in a dark room)
hard, red-eye
haloes around lights
semi-dilated non-reacting pupil
corneal oedema results in dull or hazy cornea
systemic upset may be seen, such as nausea and vomiting and even abdominal pain
There are no guidelines for the initial medical treatment emergency treatment. An example regime would be:
combination of eye drops, for example:
a direct parasympathomimetic (e.g. pilocarpine, causes contraction of the ciliary muscle → opening the trabecular meshwork → increased outflow of the aqueous humour)
a beta-blocker (e.g. timolol, decreases aqueous humour production)
an alpha-2 agonist (e.g. apraclonidine, dual mechanism, decreasing aqueous humour production and increasing uveoscleral outflow)
intravenous acetazolamide
reduces aqueous secretions
some guidelines also recommend the use of topical steroids to reduce inflammation
Definitive management
laser peripheral iridotomy
creates a tiny hole in the peripheral iris → aqueous humour flowing to the angle
Features of Addison’s disease?
lethargy, weakness, anorexia, nausea & vomiting, weight loss, ‘salt-craving’
hyperpigmentation (especially palmar creases)
ACTH is derived from a larger precursor molecule called proopiomelanocortin (POMC). When POMC is cleaved to produce ACTH, other melanocyte-stimulating hormones (MSH) are also produced. These MSHs have the effect of stimulating melanocytes in the skin to produce more melanin, the pigment responsible for skin colour
primary Addison’s is associated with hyperpigmentation whereas secondary adrenal insufficiency is not
vitiligo
loss of pubic hair in women
hypotension
hypoglycaemia
hyponatraemia and hyperkalaemia may be seen
crisis: collapse, shock, pyrexia
Tedulglutude??

Multi system atrophy types
There are 2 predominant types of multiple system atrophy
1) MSA-P - Predominant Parkinsonian features
2) MSA-C - Predominant Cerebellar features
Features of multiple system atrophy?
parkinsonism
autonomic disturbance
erectile dysfunction: often an early feature
postural hypotension
atonic bladder
cerebellar signs
Features of polymyositis?
proximal muscle weakness +/- tenderness
Raynaud’s
respiratory muscle weakness
interstitial lung disease
e.g. fibrosing alveolitis or organising pneumonia
seen in around 20% of patients and indicates a poor prognosis
dysphagia, dysphonia
Investigations for polymyositis?
elevated creatine kinase
other muscle enzymes (lactate dehydrogenase (LDH), aldolase, AST and ALT) are also elevated in 85-95% of patients
EMG
muscle biopsy
anti-synthetase antibodies
anti-Jo-1 antibodies are seen in pattern of disease associated with lung involvement, Raynaud’s and fever
Treatment for Polymyositis?
high-dose corticosteroids tapered as symptoms improve
azathioprine may be used as a steroid-sparing agent
Acute intermittent porphyria symptoms?
abdominal: abdominal pain, vomiting
neurological: motor neuropathy
psychiatric: e.g. depression
hypertension and tachycardia common
Diagnosis of Acute intermittent porphyria?
classically urine turns deep red on standing
raised urinary porphobilinogen (elevated between attacks and to a greater extent during acute attacks)
assay of red cells for porphobilinogen deaminase
raised serum levels of delta aminolaevulinic acid and porphobilinogen
Management of acute intermittent porphyria?
acute attacks
IV haematin/haem arginate
IV glucose should be used if haematin/haem arginate is not immediately available
TAKAYASU ARTERITITS
features:
Investigations:
Managment:
A large vessel vasculitis
It typically causes occlusion of the aorta and questions commonly refer to an absent limb pulse.
Features
systemic features of a vasculitis e.g. malaise, headache
unequal blood pressure in the upper limbs
carotid bruit and tenderness
absent or weak peripheral pulses
upper and lower limb claudication on exertion
aortic regurgitation (around 20%)
Associations
renal artery stenosis
Investigations
vascular imaging of the arterial tree is required to make a diagnosis of Takayasu’s arteritis
either magnetic resonance angiography (MRA) or CT angiography (CTA)
Management
steroids